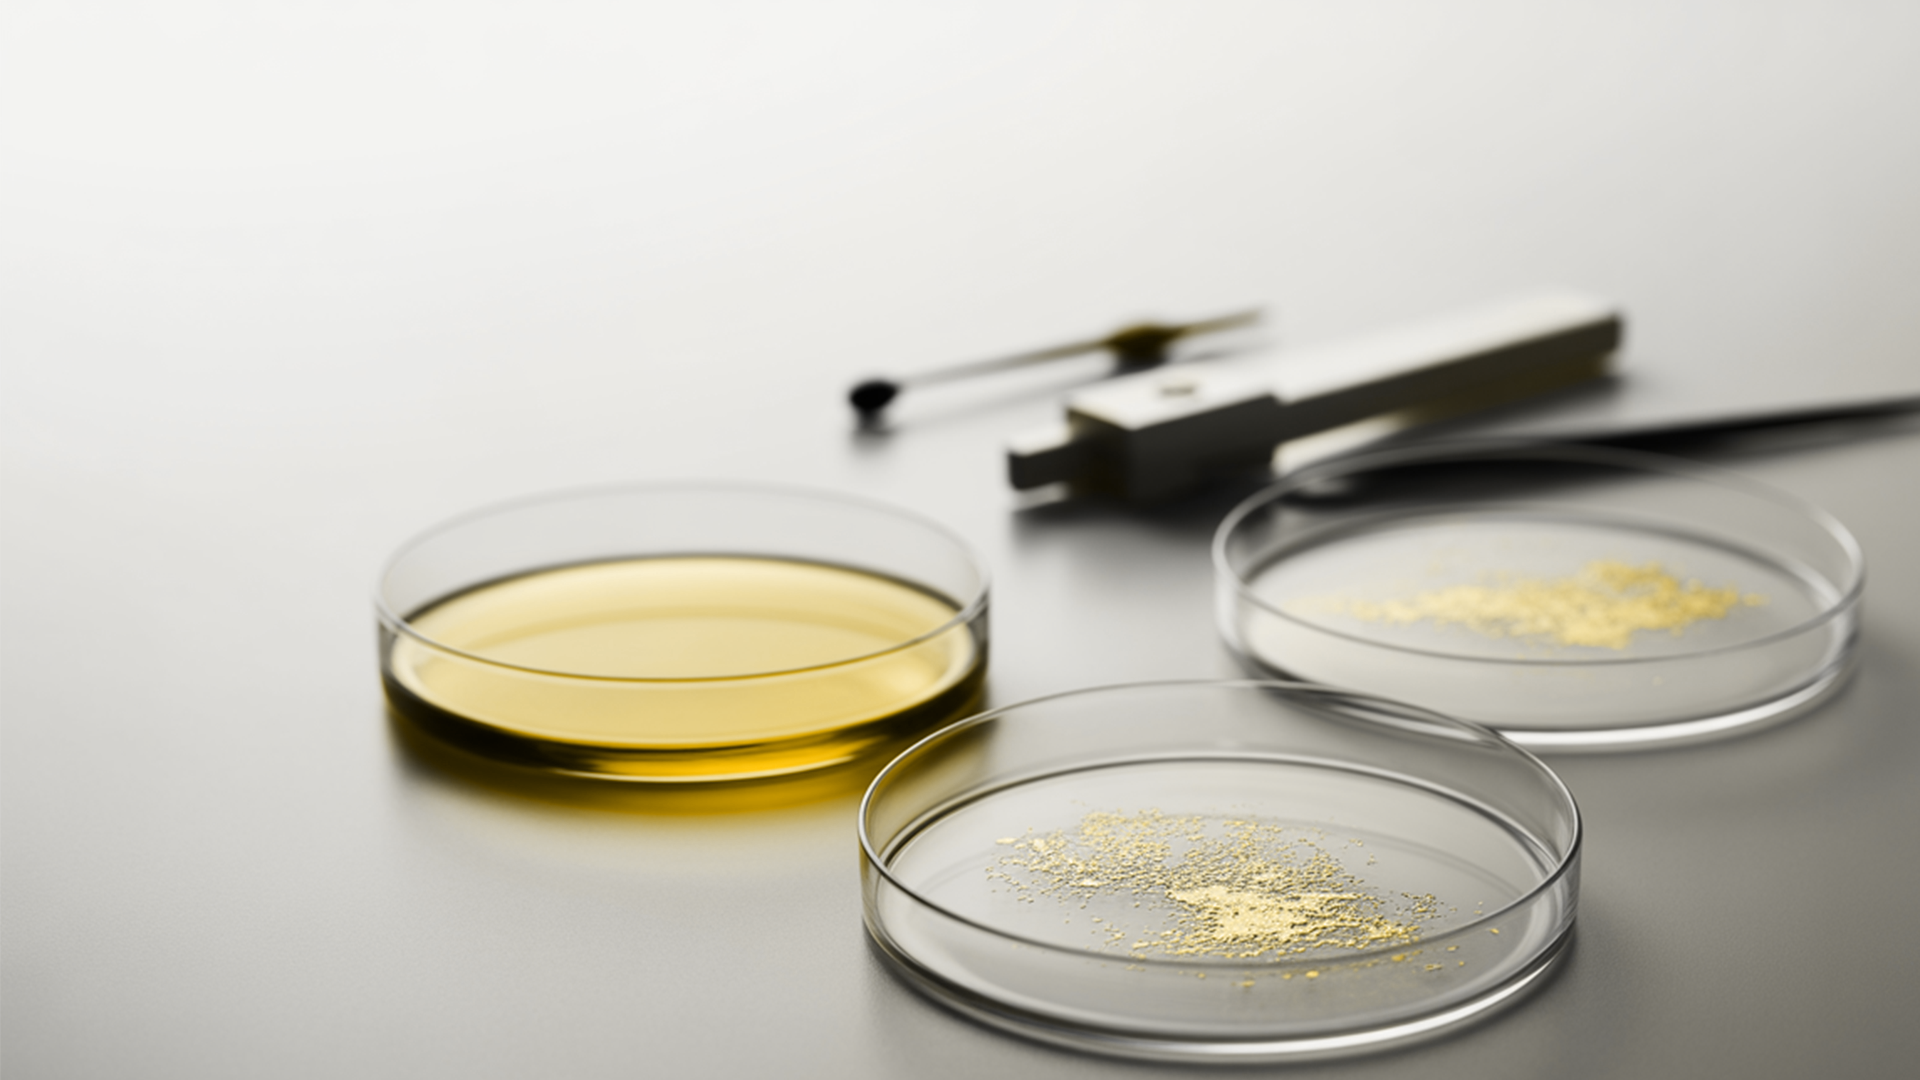

The Longevita™ Blog
We simplify complex science and the latest research in longevity into practical tips and insights you can use today.



The expert’s view
STAY INFORMED

Longevity Explained: 12 Science-Backed Answers About Healthy Ageing
What does science really say about longevity? Explore 12 evidence-based answers on ageing, NAD+, muscle, inflammation and healthspan optimisation.
Read more
The Science of Healthy Ageing: Evidence-Based Strategies to Increase Healthspan
Healthy ageing is not about simply extending lifespan. It is about increasing healthspan. This evidence-based article explores the biological hallmarks of ageing, including mitochondrial dysfunctio...
Read more
Daily Habits for Longevity (That Nobody Talks About)
When we think about longevity, the usual suspects show up: diet, exercise, sleep. But what about the habits hiding in plain sight, the ordinary practices that quietly tune your body and mind toward...
Read more
NAD+ and Longevity: The tiny molecule that helps us age better
When it comes to living a longer and healthier life, scientists are finding that some of the answers lie inside our own cells. One of the biggest stars in longevity research right now is something ...
Read more
Your Longevity Foundation: Strength, Muscle, and VO₂ Max
In our quest for a long and vibrant life, we often fixate on factors like genetics, diet, or disease avoidance. But scientific insight—from longevity experts—reveals that three physical fitness ...
Read more